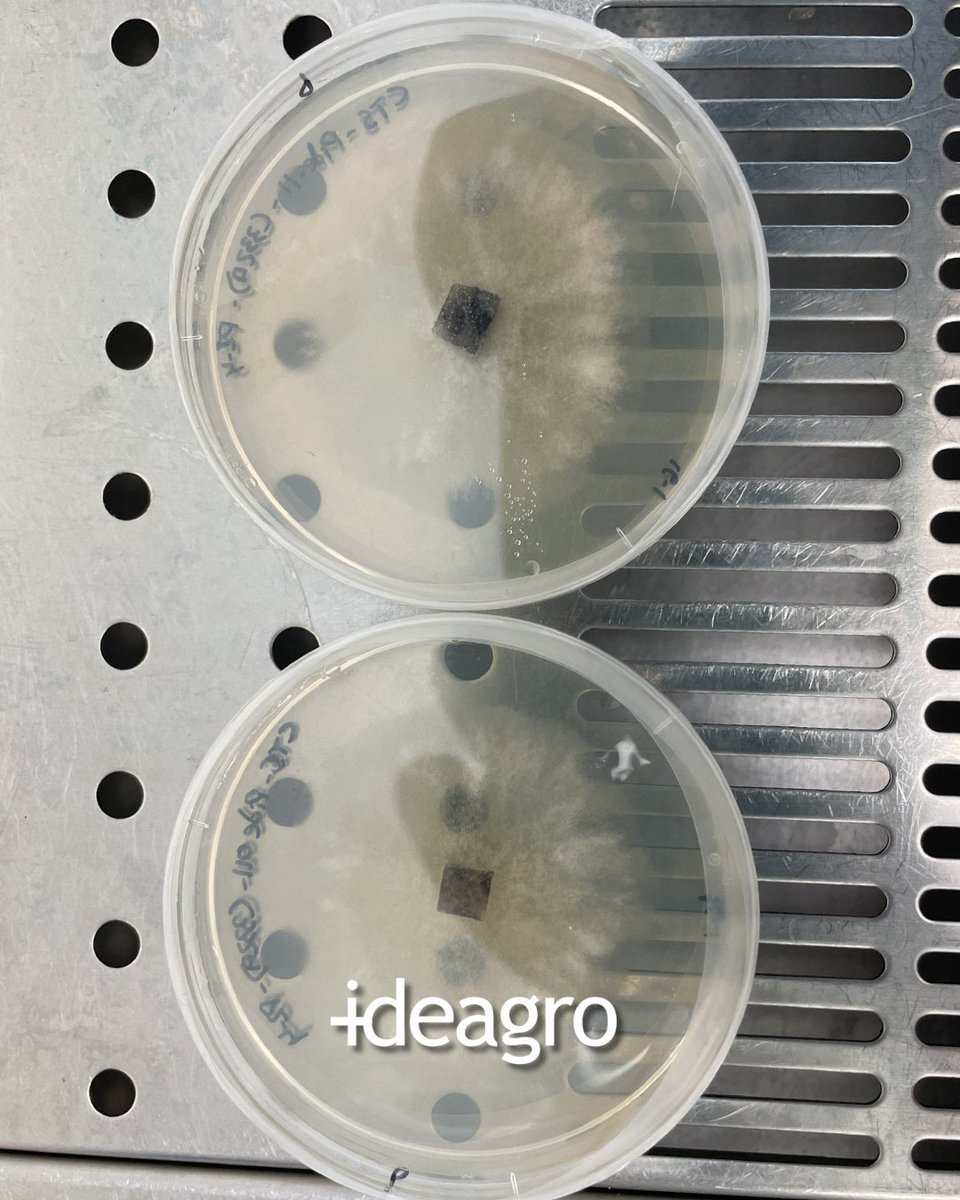
IDEAGRO tweet media
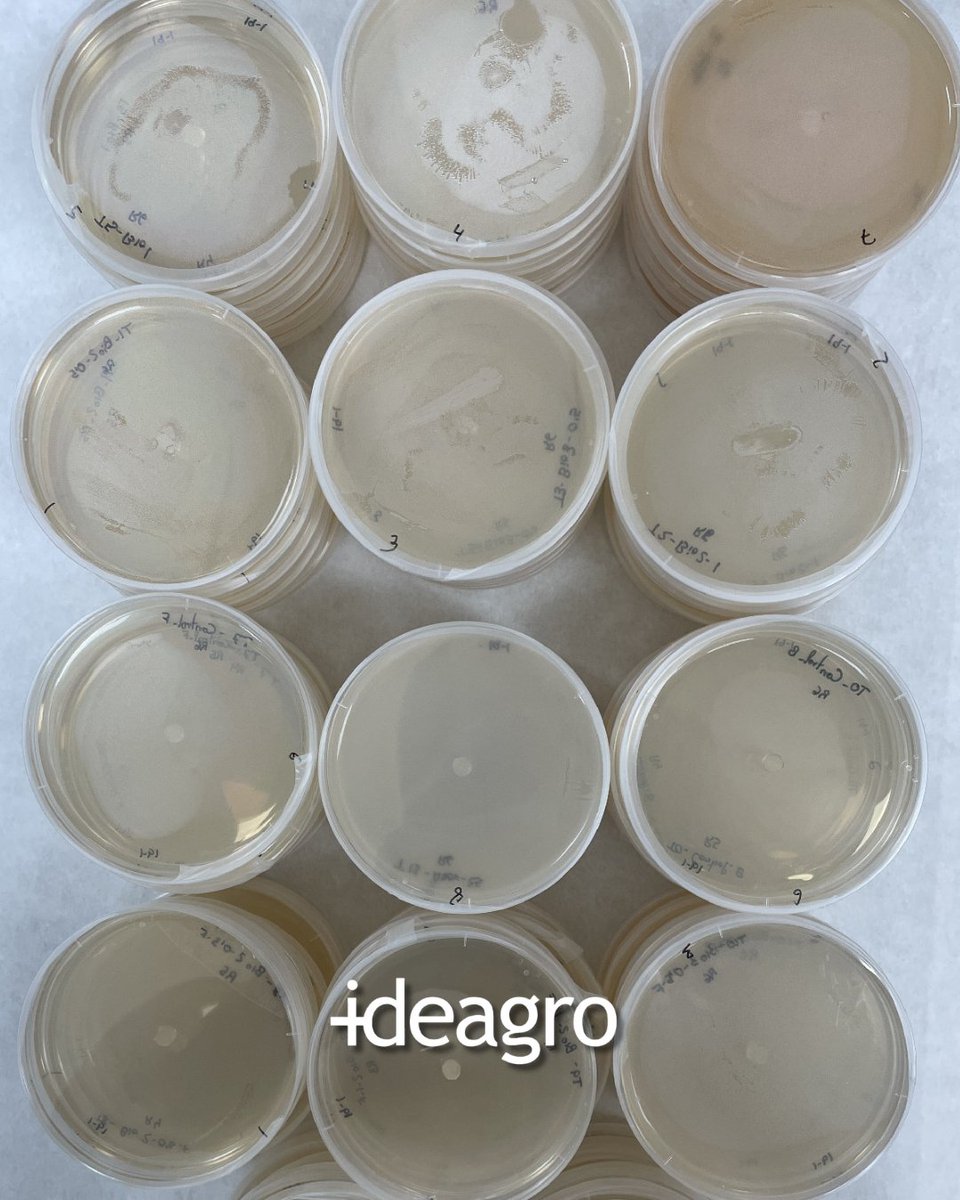
IDEAGRO tweet media
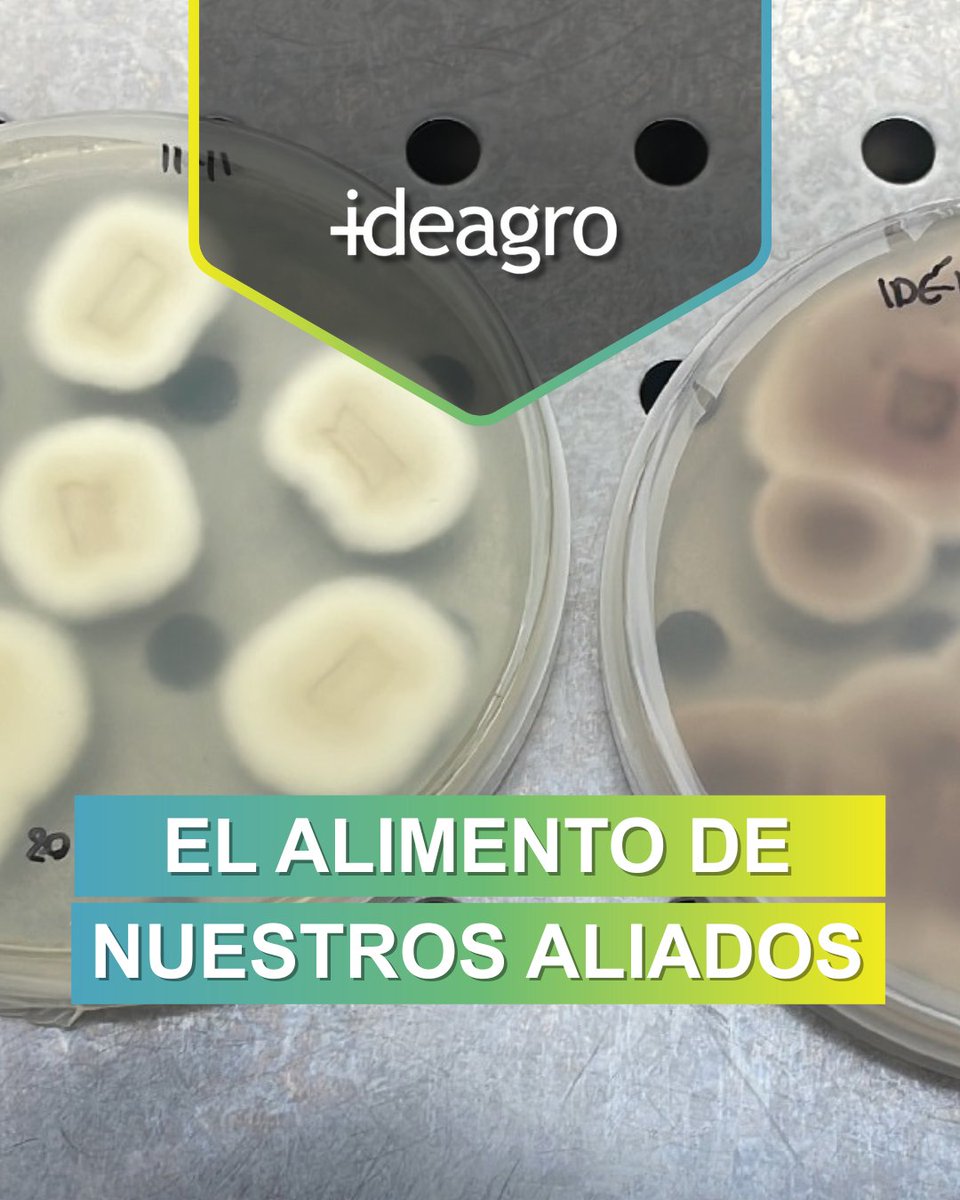
IDEAGRO tweet media

SALUD DEL SUELO, CALIDAD TOTAL
En @ideagro evaluamos cómo la biestimulación del suelo mejora la microbiología y, en consecuencia, el rendimiento y la vida postcosecha de la lechuga. Ciencia que conecta la raíz con el resultado.
#SaludDelSuelo #Postcosecha #Bioestimulantes




Español